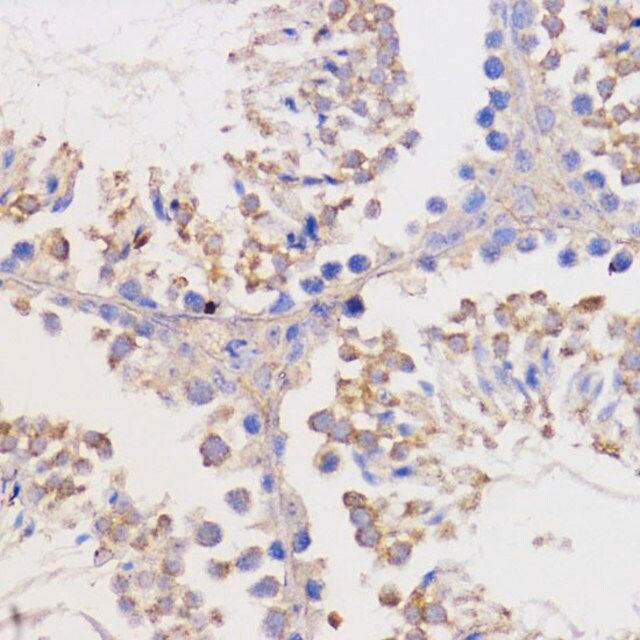

产品说明
一般描述
This gene encodes an integral outer mitochondrial membrane protein that blocks the apoptotic death of some cells such as lymphocytes. Constitutive expression of BCL2, such as in the case of translocation of BCL2 to Ig heavy chain locus, is thought to be the cause of follicular lymphoma. Alternative splicing results in multiple transcript variants.
免疫原
A synthetic peptide of human Bcl-2
外形
PBS with 0.02% sodium azide,50% glycerol,pH7.3.
储存及稳定性
Store at -20℃. Avoid freeze / thaw cycles.
产品性质
| 生物来源 | rabbit |
| 质量水平 | 100 |
| 抗体形式 | affinity isolated antibody |
| antibody product type | primary antibodies |
| 克隆 | polyclonal |
| 形式 | buffered aqueous solution |
| 分子量 | 22 26 |
| species reactivity | mouse, human, rat |
| 浓度 | 3.20 mg/ml |
| technique(s) | immunofluorescence: 1:50-1:100 immunohistochemistry: 1:50-1:100 western blot: 1:500-1:2000 |
| UniProt登记号 | P10415 |
| 运输 | wet ice |
| 储存温度 | −20℃ |
| Gene Information | human ... BCL2(596) |
安全信息
| 储存分类代码 | 12 - Non Combustible Liquids |
| WGK | WGK 1 |
| 闪点(F) | Not applicable |
| 闪点(C) | Not applicable |